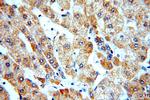
CYP26B1 Antibody in Immunohistochemistry (Paraffin) (IHC (P))

Search
Proteintech
CYP26B1 Polyclonal Antibody
{{$productOrderCtrl.translations['antibody.pdp.commerceCard.promotion.promotions']}}
{{$productOrderCtrl.translations['antibody.pdp.commerceCard.promotion.viewpromo']}}
{{$productOrderCtrl.translations['antibody.pdp.commerceCard.promotion.promocode']}}: {{promo.promoCode}} {{promo.promoTitle}} {{promo.promoDescription}}. {{$productOrderCtrl.translations['antibody.pdp.commerceCard.promotion.learnmore']}}
产品信息
21555-1-AP
种属反应
已发表种属
宿主/亚型
分类
类型
抗原
偶联物
形式
浓度
规格
纯化类型
保存液
内含物
保存条件
运输条件
产品详细信息
Immunogen sequence: KILMGEHHL VSTEWPRSTR MLLGPNTVSN SIGDIHRNKR KVFSKIFSHE ALESYLPKIQ LVIQDTLRAW SSHPEAINVY QEAQKLTFRM AIRVLLGFSI PEEDLGHLFE VYQQFVDNVF SLPVDLPFSG YRRGIQARQI LQKGLEKAIR EKLQCTQGKD YLDALDLLIE SSKEHGKEMT MQELKDGTLE LIFAAYAT (104-300 aa encoded by BC069443)
靶标信息
This gene encodes a member of the cytochrome P450 superfamily of enzymes. The cytochrome P450 proteins are monooxygenases that catalyze many reactions involved in drug metabolism and the synthesis of cholesterol, steroids and other lipids. The enzyme encoded by this gene is involved in the specific inactivation of all-trans-retinoic acid to hydroxylated forms, such as 4-oxo-, 4-OH-, and 18-OH-all-trans-retinoic acid.
仅用于科研。不用于诊断过程。未经明确授权不得转售。
生物信息学
蛋白别名: Cytochrome P450 26A2; Cytochrome P450 26B1; cytochrome P450 family 26 subfamily A member 1; Cytochrome P450 retinoic acid-inactivating 2; cytochrome P450 retinoid metabolizing protein; cytochrome P450, 26, retinoic acid B1; cytochrome P450, family 26, subfamily B, polypeptide 1; cytochrome P450, subfamily XXVIB, polypeptide 1; Cytochrome P450RAI-2; P450 26A2; retinoic acid B1; retinoic acid hydroxylase; Retinoic acid-metabolizing cytochrome; unnamed protein product
基因别名: CP26; CYP26A2; CYP26B1; P450RAI-2; P450RAI2; RHFCA
UniProt ID: (Human) Q9NR63, (Mouse) Q811W2, (Rat) G3V7X8
Entrez Gene ID: (Human) 56603, (Mouse) 232174, (Rat) 312495